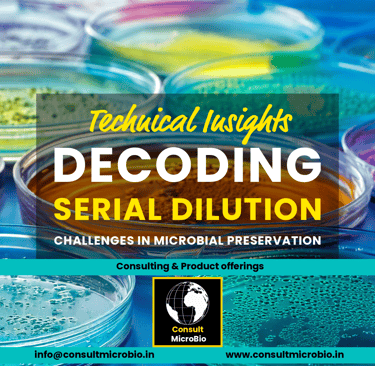

Decoding Serial Dilution-Based Microbial Culture Preservation Challenge
GOOD LABORATORY PRACTICESBEST PRACTICES FOR REFERENCE CULTURES

Decoding Serial Dilution-Based Microbial Culture Preservation Challenge
When your workflow relies on serial dilutions, the "health" of your starting material is everything. If the initial vial is compromised, every subsequent dilution amplifies that error. Storing these foundational cultures at -20°C instead of the industry-standard -80°C is often the root cause of the "drifting" results labs experience.
These fundamental principles of microbial stasis are universal, applying to Pharmaceutical, Food Safety, and Clinical Microbiology sectors across the industry.
Important Note: This blog post pertains to the preservation of active liquid or frozen cultures and cell banks. It does not apply to lyophilized (freeze-dried) pellets, which are stabilized through a different physical process and can often be stored at 2°C to 8°C until reconstitution.
Here is the breakdown of why this happens and how to stay within regulatory boundaries.
1. The Challenge: Why -20°C Fails the "Biological Pause" leads to Genetic Drift & Unexpected Mutation
Labs often report that a strain "stops working" or produces different results after a few months of storage at -20°C.
The Fact: The "Gold Standard" for halting all biological activity is the Glass Transition Temperature (Tg), is approx. -130°C to -135°C.
The Science: At Tg (-130°C), a solution enters a "glassy" state where molecular diffusion effectively hits zero.
The Gap: At -20°C, the presence of unfrozen aqueous fractions allows for residual enzymatic activity. Without the precision of active repair mechanisms, these slow-motion biochemical reactions can lead to cumulative mutations and permanent genetic drift. While -80°C is also above Tg, it follows the Arrhenius Principle: chemical reaction rates drop exponentially as you get closer to -130°C.
2. Why It Matters: High-Stakes Assays
In a GMP environment, your microbes are standardized reagents. If they mutate at -20°C, your validation fails.
Growth Promotion Testing (GPT): For example, if Pseudomonas paraeruginosa, undergoes sub-lethal injury when stored at -20°C, it shows extended lag phases. You might fail a media batch not because the media is bad, but because your culture is too weak to grow within pharmacopeial time limits.
Antimicrobial & Preservative Efficacy (AET/PET): Mutations can change cell wall permeability. A "hardy survivor" from a -20°C freezer might show artificial resistance, leading to a false-fail in your preservative study.
Antibiotic Potency Assays: These assays rely on precise sensitivity. Genetic drift at -20°C can change a strain's Minimum Inhibitory Concentration (MIC), rendering your calculations invalid.
Disinfectant Efficacy Testing (DET): Phenotypic drift can make a disinfectant appear ineffective against a lab strain, even though it meets standards against an authentic source.
Sterilization Validation: Storing stocks like Geobacillus stearothermophilus at -20°C can lead to a loss of heat resistance (D-value), meaning your sterilization cycle is no longer being challenged correctly.
Environmental Isolates (House Flora): Cleanroom "wild" isolates are highly adapted. Storing them at -20°C often leads to the loss of the specific characteristics that made them significant enough to track.
3. The Challenge: Mechanical Damage & Selective Pressure
The Fact: Standard -20°C freezers use "auto-defrost" cycles causing recrystallization, where small ice crystals fuse into larger, jagged structures that rupture cell membranes.
The Science: Because -20°C is close to the melting point of the "salty" liquid inside a cell, these cycles cause micro-thaws. Water refreezes into jagged ice crystals that physically shred cell structures.
The Selective Pressure: High-performing cells die off at -20°C, leaving behind "hardy survivors" that may have shed expensive plasmids just to stay alive.
Key Takeaway for Regulatory Compliance
To meet regulatory expectations from FDA (21 CFR 610.18), EMA, and ISO 17025, labs must demonstrate that strains have not drifted. Storage at –20 °C poses a regulatory risk because it fails to achieve vitrification (~ –130 °C). To ensure compliance and maintain strain stability, cultures should be stored at –80 °C or lower to place the biology into a true metabolic pause.
Disclaimer: This information is intended for educational use and general guidance. Because preservation needs can vary widely, it’s essential for users to confirm these details against the specific requirements of their organisms, their own internal SOPs, and the latest applicable regulatory guidelines before adjusting any preservation protocols.
